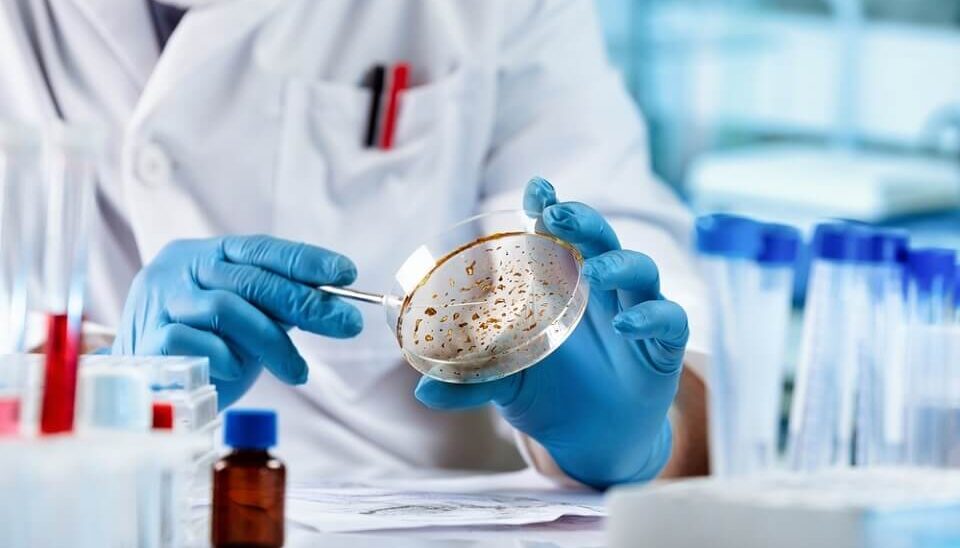

Departments

Obstetrics and Gynaecology and Infertility
This Department deals with problems of females. All disorders related To Irregular periods, excessive bleeding, other harmonal disorders, pregnancy, child Birth, post partum Care, Infertility are handled with medical as well as surgical treatment.

Orthopaedics and Joint Replacement
This department offers specialized care in the field of complex trauma, poly-trauma and related sub-specialities. Orthopaedic department at our hospital delivers personalised care utilising latest research and evidence-based medicine.

Cardiology
Our specialist is dedicated to providing personalized care and comprehensive evaluations to address all your cardiac concerns. Whether you’re seeking preventative advice, managing a heart condition, or need a second opinion, our team is here to support you every step of the way.

General & Laparoscopy Surgery
The department deals with a range of surgical ailments and emergencies. In addition to treating minor swellings, the surgeons are adept at complex abdominal surgeries and trauma cases. Most abdominal surgeries are performed through laparoscopy (keyhole surgery).

Pathology
The Pathology Department at Shri Sai Hospital provides a range of services related to the diagnosis and management of diseases.

Dentistry and Implants
Our Dental department is growing from strength to strength, constantly adding equipment, incorporating technology and re-inventing itself.

General Medicine
We have the most advanced technology available at our hospital. Often, patients can have diagnostic investigations at the same visit as their initial consultation with one of the medical specialists and highly skilled and committed staff.

Anaesthesiology
his department deals with all types of critical problems like respiratory failure , sepsis, hypotension , severe trauma cases , cardiac emergencies , terminally sick patients , post surgical serious patients

Urology
Our Urologists are trained in open and minimally invasive surgical techniques, employing real-time ultrasound guidance, fiber-optic endoscopic equipment, and various lasers in the treatment of multiple benign and malignant conditions.

Dermatology
The Dermatology Department at Shri Sai Hospital provides a range of services to address various skin, hair, and nail conditions.

Paediatrics
This department deals with medical problems of neonates and children up to 16 yr of age .
All problems like loss of appetite, anaemia, growth retardation, pain abdomen , recurrent infections , asthma , rheumatic diseases etc are managed .

Ear Nose and Throat – ENT
This department deals with diseases related to ear, nose and throat and related surgeries.
Ear : hearing testing, complete endoscopic ear check up, foreign body removal, Myringoplasty, tympanoplasty, mastoidectomy, stapes surgery

Ophthalmology – Eye
The department is handled by consultant eye surgeon who visits twice a week and two experienced optometrists who takes care of eye problems 24/7.

Pulmonology
The Pulmonology Department is a specialized unit that focuses on the diagnosis and treatment of diseases related to the respiratory system.

Plastic Surgery
The Plastic Surgery Department at Shri Sai Hospital offers a range of services to meet various cosmetic and reconstructive needs.

Neurosurgery
The Neurology Department at Shri Sai Hospital is committed to providing comprehensive and compassionate care to patients with neurological conditions, ensuring the best possible outcomes.

Nephrology
The Nephrology department at Shri Sai Hospital offers comprehensive services for the diagnosis, treatment, and management of various kidney-related disorders.

Oncology
The Medical Oncology Department at Shri Sai Hospital offers comprehensive services for the diagnosis, treatment, and management of cancer.

Endocrinology
The Endocrinology Department at Shri Sai Hospital provides comprehensive care for patients with endocrine disorders.